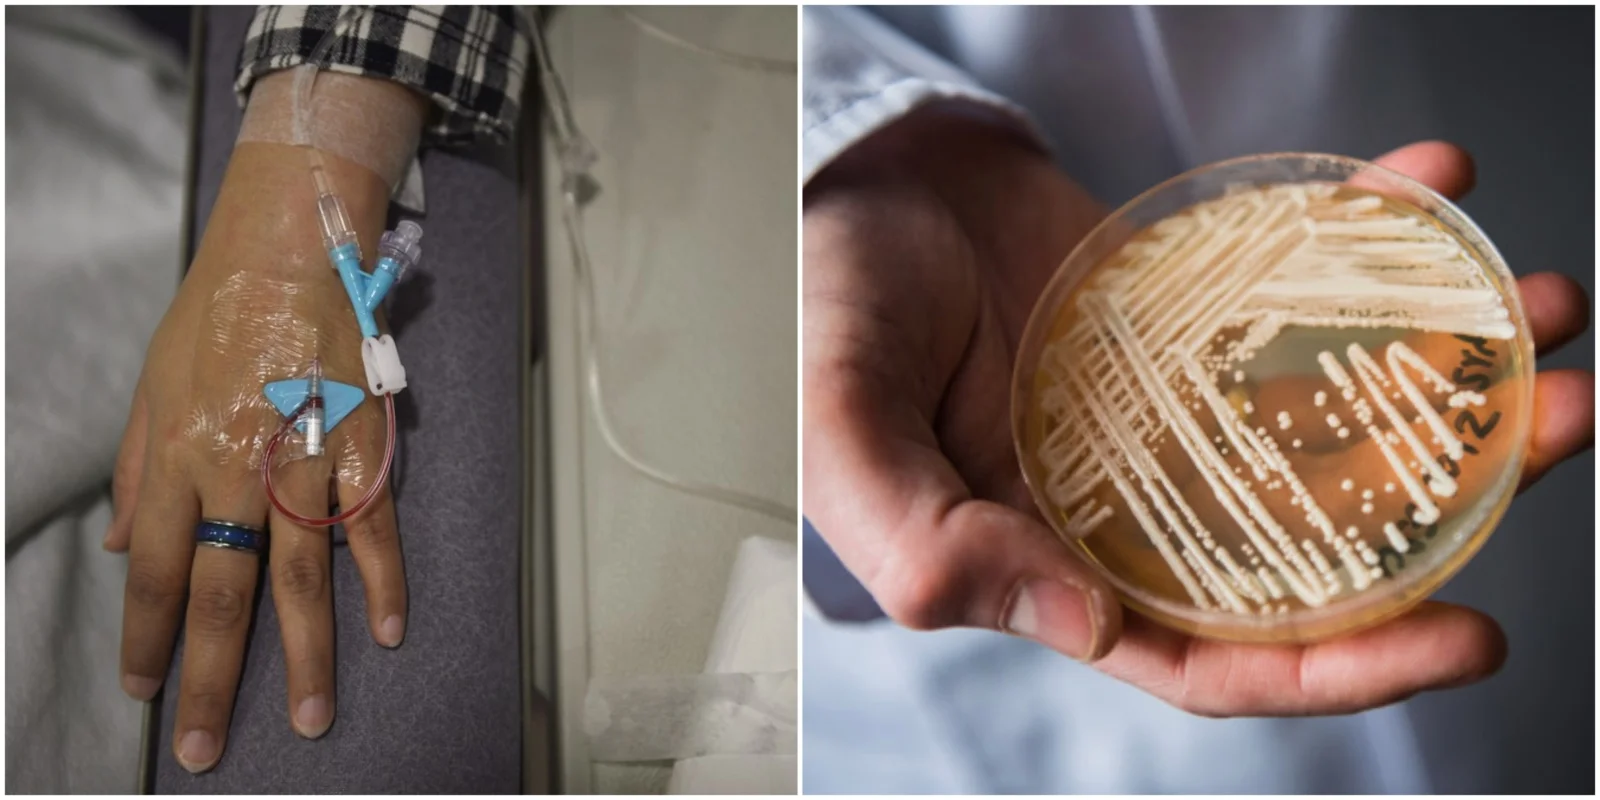

ევროპის ჯანდაცვის ახალი კვლევა საგანგაშო ტენდენციას ავლენს: საშიში, წამლებისადმი რეზისტენტული სოკო, Candida auris, კონტინენტის საავადმყოფოებში სწრაფად ვრცელდება. შემთხვევებისა და შიდაჰოსპიტალური აფეთქებების რიცხვი იზრდება, ზოგიერთ ქვეყანაში კი უკვე მუდმივი ლოკალური გადაცემა ფიქსირდება. გაეცანით ევრიპის დაავადებათა კონტროლისა და პრევენციის ცენტრის განცხადებას.
რა არის Candida auris?
C. auris არის საფუარა სოკოს სახეობა, რომელიც პირველად 2009 წელს, იაპონელი პაციენტის ყურის ნაცხში აღმოაჩინეს. მას შემდეგ ის 40-ზე მეტ ქვეყანაში გავრცელდა. მიუხედავად იმისა, რომ საფუარა სოკოების უმეტესობა ადამიანის ჯანმრთელი მიკრობიომის ნაწილია, C. auris ბევრად უფრო საშიშია. ჯანმრთელ ადამიანებში ის, როგორც წესი, მსუბუქ ინფექციას იწვევს, მაგრამ დასუსტებული იმუნიტეტის მქონე პაციენტებისთვის შეიძლება მომაკვდინებელი აღმოჩნდეს, განსაკუთრებით მაშინ, როდესაც ის სისხლის მიმოქცევაში ან სასიცოცხლო ორგანოებში ხვდება.
რატომ არის ის ასეთი საშიში და რთულად მოსაშორებელი?
C. auris-ის მთავარი საფრთხეებია:
- მაღალი სიკვდილიანობა: ინვაზიური ინფექციების დროს სიკვდილიანობის მაჩვენებელი 30%-დან 60%-მდე მერყეობს.
- წამლებისადმი რეზისტენტობა: ზოგიერთი შტამი მდგრადია თითქმის ყველა არსებული სოკოს საწინააღმდეგო მედიკამენტის მიმართ.
- გავრცელების სიმარტივე: ვრცელდება ინფიცირებულ ადამიანთან ან დაბინძურებულ ზედაპირებთან პირდაპირი კონტაქტით. ის გამოიმუშავებს ცილებს, რომლებიც ეხმარება ზედაპირებზე “მიწებებაში” და უძლებს სტანდარტულ სადეზინფექციო საშუალებებს.
- რთული დიაგნოსტიკა: სტანდარტული ლაბორატორიული ტესტები მას ხშირად შეცდომით სხვა, უფრო გავრცელებულ საფუარა სოკოდ მიიჩნევენ, რაც სწორ იდენტიფიკაციას ართულებს.
გავრცელების მასშტაბი
C. auris ევროპაში სწრაფად გავრცელდა. 2013-2023 წლებში 4,000-ზე მეტი შემთხვევა დაფიქსირდა, აქედან 1,300 მხოლოდ 2023 წელს. დიდ ბრიტანეთში, ბოლო მონაცემებით, შემთხვევების 23%-იანი ზრდა აღინიშნა. ზოგიერთ ქვეყანაში სოკო უკვე ენდემური გახდა საავადმყოფოებში. გლობალურად კი ის ანტარქტიდის გარდა ყველა კონტინენტზეა ნაპოვნი.
რას აკეთებენ ჯანდაცვის უწყებები?
ჯანდაცვის უწყებები საფრთხეს აღიარებენ. ევროპის დაავადებათა პრევენციისა და კონტროლის ცენტრმა (ECDC) უფრო მკაცრი ზედამხედველობისკენ მოუწოდა, ხოლო ჯანმრთელობის მსოფლიო ორგანიზაციამ C. auris პრიორიტეტული სოკოვანი პათოგენების სიაში შეიყვანა.
ექსპერტების თქმით, არსებობს “კრიტიკული ფანჯარა”, როდესაც მკაცრი ზომებით შესაძლებელია ერთეული შემთხვევის ან მცირე აფეთქების შეჩერება. თუმცა, თუ C. auris საავადმყოფოში ან რეგიონში ფართოდ გავრცელდება, მისი შეჩერება უკიდურესად რთული ხდება. თუ მას უკონტროლოდ გავრცელების საშუალება მიეცემა, ის შეიძლება მუდმივ საფრთხედ იქცეს, რაც გამოიწვევს ხშირ აფეთქებებს, გაზრდილ ხარჯებს, ავადობასა და სიკვდილიანობას.